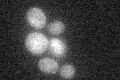
YNL187W
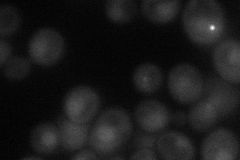
YNL187W
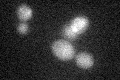
YNL187W
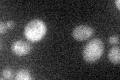
YNL187W

View description
Protein involved in mRNA splicing; contains a consensus nuclear export signal (NES) sequence similar to the consensus sequence recognized by Crm1p; interacts genetically with Prp40p and Tgs1p; contains WD40 repeats
Localization:
Intensity:
Fold change:
Significance:
-
C’ GFP library in SD
below threshold18.35 -
N' NOP1pr-GFP in SD
cytosol,punctate,nucleus32.7132 -
N' TEF2pr-mCherry in SD

cytosol,punctate,nucleus13.4665 -
N' NATIVEpr-GFP in SD

below threshold16.5976 -
N' TEF2pr-VC and Cyto-VN in SD

below threshold25.4705 -
C’ GFP library in SD+DTT

cytosol18.371No -
C’ GFP library in SD+H2O2
cytosol19.571.06No -
C’ GFP library in Starvation Media
cytosol26.71.45No -
C’ GFP library on the background of Pup2-DaMP

below threshold -
C’ GFP library on the background of CCT mutant

below threshold18.02860.982003No
